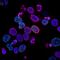
Células son reprogramadas para atacar al cáncer de páncreas

¿Qué es Revumenib? Se trata de una pastilla experimental de la que según lo apuntado en resultados de estudios, ha logrado la remisión completa en pacientes con leucemia.
Los resultados de un reciente ensayo clínico indican que el Revumenib, logró en algunos casos un grado de remisión completa en personas diagnosticadas con leucemia.
Sin embargo, debido a que aún se trata de una pastilla experimental, en el mismo estudio se encontraron posibles indicios de que la leucemia podría generar resistencia al tratamiento.

Un grupo de 18 pacientes con leucemia lograron la remisión completa al tomar el Revumenib
Un total de 18 pacientes con leucemia mieloide aguda avanzada, tuvieron una remisión completa tras someterse a un tratamiento con Revumenib, una pastilla experimental.
De acuerdo con lo publicado por la revista especializada, Nature, se desarrollaron un par de estudios en torno al Revumenib que forman parte de la fase 1 de un ensayo clínico.
La publicación refiere que en los estudios participaron un total de 60 personas con diagnóstico de leucemia mieloide, quienes recibieron la pastilla experimental.
Del total de personas que tomaron el Revumenib, un grupo de 18 consiguió la remisión completa de la leucemia, aunque no se trató del único resultado ante el tratamiento.
Sobre ello, se indicó que otro 53 por ciento de las personas que fueron parte del ensayo clínico con el Revumenib, mostraron algún grado de remisión.
Debido a lo anterior, como parte de las conclusiones del estudio se determinó que el Revumenib reveló “efectos anticancerígenos”, pero también “posibles indicios de resistencia”.
Estudios advierten que pacientes que recibieron revumenib también generaron resistencia al tratamiento
Según lo asentado en los estudios, el Revumenib demostró tener una capacidad de reducción de una proteína denominada menina, la cual es clave para la generación de la leucemia.
Al respecto, la información publicada en la revista Nature establece que la pastilla experimental antes conocida como SNDX-5613, genera reordenamientos KMT2A o NPM1 mutante.
Ghayas Issa, de la Universidad de Texas, quien encabezó el primer estudio, refirió que la tasa de respuesta del Revumenib, es la más alta observada en cualquier monoterapia contra la leucemia.
Por su parte, Scott Armstrong del Instituto Oncológico Dana Farber, quien encabezó el segundo estudio, profundizó en la aparición de resistencia selectiva a la inhibición de la menina.
Ante ello, dijo que se identificaron mutaciones específicas en el gen MEN1 que codifica la menina, las cuales podrían ser indicios de que existe resistencia al tratamiento.
Y es que resaltó que las mutaciones se detectaron en varios pacientes que en un principio respondieron de manera alentadora al tratamiento, pero no mantuvieron la mejoría.
Al identificar estas vías de escape del tratamiento, se obtuvo información valiosa que será necesaria para mejorar los resultados de los pacientes en el futuro, concluyó.